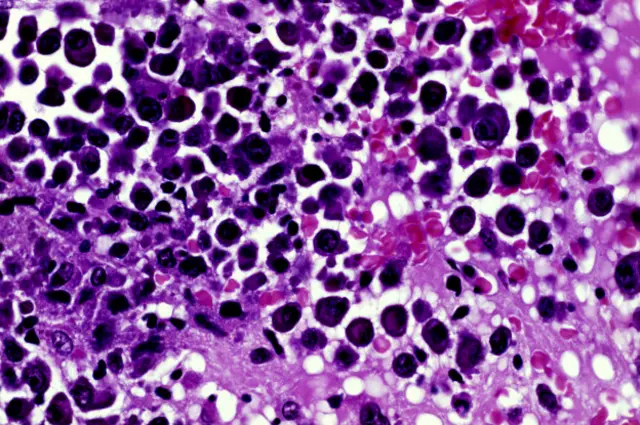
Миелома

Контрафакт или экономия: баталии вокруг препарата от рака в России
Автор фото, Science Photo Library
- Автор, Ольга Слободчикова
- Место работы, Русская служба Би-би-си
- Опубликовано
Ассоциация международных фармацевтических производителей выразила протест регистрации в России противоракового препарата "Метибластан", увидев в этом нарушение патента американской биотехнологической компании "Селджен".
Как заявляют в российском представительстве компании, министерство здравоохранения открыло дорогу контрафактному, как они его называют, препарату для участия в многомиллиардных госзакупках по федеральной программе "Семь нозологий", в которую включены высокозатратные заболевания.
В министерстве здравоохранения Би-би-си заявили, что не наделены какими-либо полномочиями в сфере защиты прав интеллектуальной собственности.
Препарат аргентинского производства был <link type="page"><caption> зарегистрирован</caption><url href="http://grls.rosminzdrav.ru/Grls_View_v2.aspx?idReg=1397945&t=" platform="highweb"/></link> в апреле, а 23 мая ему установили предельную цену - <link type="page"><caption> почти на 20%</caption><url href="http://grls.rosminzdrav.ru/PriceLims.aspx?Torg=&Mnn=%D0%9B%D0%B5%D0%BD%D0%B0%D0%BB%D0%B8%D0%B4%D0%BE%D0%BC%D0%B8%D0%B4&RegNum=&Mnf=&Barcode=&Order=&isActual=0&All=0&PageSize=8&orderby=pklimprice&orderType=desc&pagenum=1" platform="highweb"/></link> меньшую, чем у оригинального "Ревлимида", который в России производит "Селджен".
При этом патент на "Ревлимид" истекает только в июле 2022 года. "Селджен" уже обратился в Арбитражный суд Москвы и в Федеральную антимонопольную службу.
В свою очередь компании-конкуренты подали заявления в Роспатент с просьбой признать патенты на "Ревлимид" недействительными.
"Интеллектуальное рейдерство" - такую фразу журналистам на пресс-конференции в пятницу предложил использовать глава Ассоциации международных фармацевтических производителей (AIPM) Владимир Шипков.
Эксперты фарминдустрии, опрошенные Русской службой Би-би-си, сомневаются в судебных перспективах этого спора. Если аргентинскому производителю удалось синтезировать препарат иным способом, чем компании "Селджен", это не является нарушением патента, отметил генеральный директор компании DSM Group Сергей Шуляк.
Вопрос на шесть миллиардов
И "Ревлимид", и "Метибластан" - торговые наименования иммуномодулирующего препарата леналидомид, который используется для лечения множественной миеломы. Это заболевание системы крови, при котором в костном мозге собираются аномальные плазматические клетки: они препятствуют производству нормальных клеток крови и приводят к поражению костей.
"Леналидомид" <link type="page"><caption> вошел</caption><url href="http://www.dsm.ru/docs/analytics/Annual_report_2015_DSM_web.pdf" platform="highweb"/></link> в список лекарств, покупаемых в рамках программы "Семь нозологий", в марте прошлого года. До конца 2015-го минздрав закупил его у "Селджен" на сумму 7,8 млрд рублей (119 млн долларов), свидетельствуют данные базы "СПАРК-Интерфакс".
Теперь американская компания готовится участвовать в <link type="page"><caption> новом аукционе</caption><url href="http://www.zakupki.gov.ru/epz/order/notice/ea44/view/common-info.html?regNumber=0195100000216000058" platform="highweb"/></link> - с начальной ценой контракта почти в 6 млрд рублей. В "Селджен" предполагают, что ускоренная регистрация "Метибластана" связана с намерением его производителей составить на этом аукционе конкуренцию оригинальному препарату.
География компаний, связанных с "Метибластаном", чрезвычайно широка. Субстанцию для него везут из Индии, а сам препарат производит в Буэнос-Айресе компания Laboratorio Tuteur S.A.C.I.F.I.A. (в регистрационных документах минздрава - "Лаборатория Тютор С.а.С.И.Ф.И.А."). В Аргентине он выпускается как <link type="page"><caption> Lunadin</caption><url href="http://web.tuteur.com.ar/ru/productos/115" platform="highweb"/></link>.

Пакуют лекарство в Кургане, а обращаться с претензиями нужно в московское представительство швейцарской компании с российскими владельцами "Генфа Медика".
Для "Лаборатории Тютор" Россия - <link type="page"><caption> основной зарубежный рынок сбыта</caption><url href="http://pharmaboardroom.com/interviews/tuteur-edgardo-taraciuk-vice-president-of-laboratorios-argentina/" platform="highweb"/></link>, куда компания поставляет несколько десятков препаратов. Вместе с "Генфа Медика" она уже регистрировала в России лекарство до окончания действия патента - дженерик широко используемого противолейкозного препарата "Гливек" компании Novartis.
Аукцион по госзакупке леналидомида изначально планировалось провести в апреле, однако затем его перенесли на 9 июня, обращает внимание гендиректор представительства "Седлжен" Виктор Феркович.
По данным газеты РБК, директор представительства "Генфа Медика" Елена Черных <link type="page"><caption> обратилась в ФАС</caption><url href="http://www.rbc.ru/business/26/05/2016/574606899a79475a7eeb63b6?from=newsfeed" platform="highweb"/></link> с просьбой перенести аукцион на более позднюю дату, поскольку участие в нем нового дженерика позволит получить экономию бюджетных средств в размере как минимум 20% от начальной стоимости лота, что составит порядка 1,6 млрд рублей.
"Генфа" 13 апреля подала заявление в Роспатент, оспаривая эксклюзивные права "Селджен" на выпуск леналидомида. По мнению компании, объект защиты, то есть "Ревлимид", частично не соответствует критериям патентоспособности.
При назначении сроков аукциона минздрав руководствовался интересами пациентов, следует из ответа министерства на запрос Би-би-си.
"В рамках процедуры регистрации лекарственного препарата и предельных отпускных цен на него министерство здравоохранения РФ не обладает полномочиями по контролю соблюдения требований законодательства в сфере защиты прав интеллектуальной собственности, - говорится в сообщении.
"Конкурентные разборки"
Сторону производителей "Ревлимида" заняла, в частности, Национальная ассоциация организаций больных редкими заболеваниями "Генетика". Некоторые пациенты посчитали, что станут "подопытными крысами", поскольку препарат, по их мнению, не прошел достаточных клинических испытаний, заявила вице-президент объединения Альбина Макаева.
В свою очередь в компании "Генфа" заявляют, что все необходимые для регистрации в России клинические испытания препарат прошёл.
Как считает директор НИИ организации здравоохранения и медицинского менеджмента Давид Мелик-Гусейнов, то, что государство заинтересовано в экономии средств, - это нормальное явление.
"Никто не хочет сэкономить за счет непролеченных пациентов. За один условный рубль хотят купить больше пачек препарата. Экономить - это нормальная потребность государства, но другое дело, что с ней нельзя перегнуть палку, нельзя допускать на рынок некачественный препарат. Но если есть более дешевый качественный препарат, государство обязано его закупить", - сказал эксперт.
По его мнению, коллизия вокруг "Ревлимида" и "Метибластана" - это всего лишь конкурентные разборки между условными "новаторами" и производителями дженериков.
"Таких случаев очень много сегодня не только в России, но и в мире. Борьба идет за право быть первым в секторе дженериков. Это борьба очень жестокая, потому что речь идет о многих и многих миллиардах долларов", - констатирует Мелик-Гусейнов.
"Когда инновационный препарат теряет статус защиты патента, на его рынке дженерики возникают сразу. Важно первым появиться на этом рынке, потому что во многих странах мира существует такое специфическое ценообразование, когда цена первых дженериков на 25% ниже, чем оригинального, а следующие дженерики еще на 25% должны быть дешевле, чем первые два", - продолжил он.
Нарушением патента является лишь копирование технологии, подчеркивает в свою очередь Сергей Шуляк.
"Если доказано, что препарат был синтезирован другим способом, нежели оригинальный препарат, то здесь нет нарушения патента. Иными словами, если кто-то смог повторить молекулу каким-то другим способом, то нарушения не происходит. В мире было много судебных решений по этому поводу", - сказал он.
Он сомневается, что какая-либо компания пошла бы на регистрацию своей версии запатентованного препарата, если бы он был просто скопирован, поскольку ей могли бы грозить огромные штрафы. При этом, по словам Шуляка, случаи, когда молекула какого-либо запатентованного препарата синтезируется новым способом, чрезвычайно редки, за исключением сферы биотехнологических препаратов.
В судах споры "новаторов" и производителей дженериков очень часто рассыпаются, потому что обе стороны могут предоставить аргументы, объясняющие их позиции, добавил Мелик-Гусейнов.




















